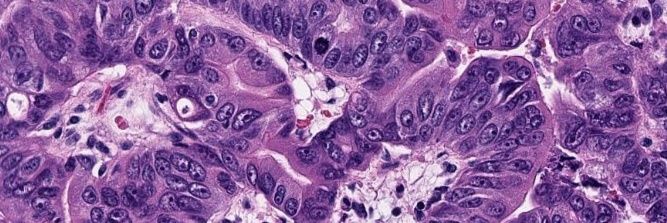
Georgia Association of Pathology (GAP) banner

Enjoy GAPs May newsletter to get the latest stories from digital pathology and molecular findings in RCC to our Trainee's Corner! Click here to read!
pathologyconnection.com/docs/gap/2024-…
#pathology #pathmatch

English
Georgia Association of Pathology (GAP)
573 posts

@GAPathologists
We aim to be the voice of Georgia #pathologists 🔬🧬🧫 | #Pathology News + Events + #GAPCoTM | Follow us on 🐦 + 📷






































